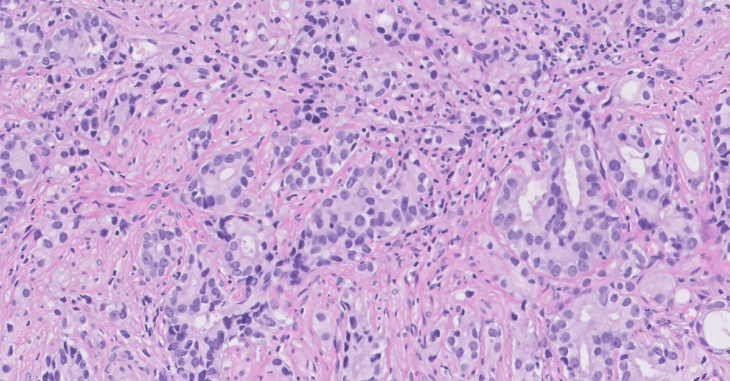

Newsroom

About Visiopharm
Visiopharm’s pioneering image analysis tools support thousands of scientists, pathologists, and image analysis experts in academic institutions, biopharmaceutical industry, and diagnostic centers. AI-based image analysis and tissue mining tools support research and drug development research worldwide, while CE-IVD APPs support primary diagnostics. With the most advanced and sophisticated artificial intelligence and deep learning, Visiopharm delivers tissue data mining tools, precision results, and workflows.
Visiopharm was founded in 2001 and is privately owned. The company operates internationally with over 900 licenses and countless users in more than 40 countries. The company headquarters are in Denmark’s Medicon Valley, with offices in Sweden, England, Germany, and the United States.
Contact us



